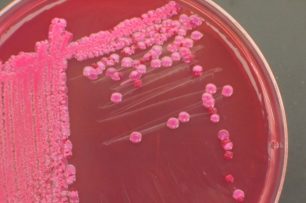
que-es-un-urocultivo-e1468333962817-640x425

La infección del tracto urinario (ITU) consiste en la colonización y multiplicación microbiana, habitualmente bacteriana, a lo largo del trayecto del tracto urinario. Se denomina pielonefritis si afecta al riñón y la pelvis renal, cistitis si implica a la vejiga, utetritis si afecta a la uretra y prostatitis si la infección se localiza en la próstata.
PREVALENCIA
- Son las más frecuentes cuando usamos sondas (infecciones nocosomiales)
- Son más frecuentes en el sexo femenino: hasta un 50 % de las mujeres puede presentar una ITU a lo largo de su vida, lo que se relaciona con la actividad sexual, los embarazos y la edad. Un 15% de las mujeres padecen un episodio de ITU cada año, y un 25% tiene una repetición anual.
- En el varón las ITU tienen dos picos de incidencia; durante el primer año de vida y en mayores de 50 años (relacionado con problemas de próstata o manipulaciones urológicas).
CLASIFICACIÓN CLÍNICA
|
POR SU LOCALIZACIÓN |
|
| Inferiores o de Vías Bajas: | Superiores o de Vías Altas: |
| Cistitis | Pielonefritis Aguda |
| Uretritis | Nefritis Bacteriana Aguda Focal ó Difusa |
| Prostatitis
|
Absceso Intrarrenal
Absceso Perinéfrico |
OTRA CLASIFICACIÓN: ITU COMPLICADA VERSUS NO-COMPLICADA
- ITU No Complicada: Esencialmente son las IU del tracto inferior (cistitis/uretritis).
Aparece en mujeres jóvenes sanas, no embarazadas y con síntomas de al menos 7 días de evolución. Responden a un tratamiento corto de 3 días.
- ITU Complicada:
Las personas pueden tener las vías urinarias normales pero padecer diabetes, inmunosupresión, niños, ancianos, con síntromas de más de 7 días, hospitalizaciones,. Se dá mas en varones.
Aparece en personas con vías urinarias anormales como por ejm obstrucción, reflujo, vejiga neurógena, cálculos o embarazo.
ETIOLOGÍA
1- ITU adquirida en la comunidad
La Escherichia Coli es el germen causal que se encuentra con más frecuencia en especial en las IU ambulatorias no complicadas (80-90%).

El resto de las infecciones son producidas por otras enterobacterias como el Proteus mirabilis y Klebsiella spp. El Estreptococus saprophytus es frecuente en mujeres con actividad sexual. El Proteus mirabilis es habitual en niños varones recién nacidos menores de 2 años. El Enterococo faecalis es frecuente en sujetos ancianos con síndrome prostático.
2- ITU adquirida en el hospital
La Escherichia Coli se aisla en el 50% de los casos. En el resto puede aparecer Enterobacter, Citrobacter, Pseudomona aeruginosa, Serratia, Providencia, Morganella y gérmenes gram positivos como Enterococo, Estreptococo y Estafilococo epidermidis. La proporción de infecciones causadas por Candida está incrementada;los factores de riesgo de infección por Candida son:
a) sondaje, b) instrumentación de la vía urinaria, c) diabetes, d) tratamiento antibiótico, y e) trasplante renal.
DIAGNÓSTICO
1- RÁPIDO -tira de leucocitoesterasa

2- UROCULTIVO:
Cistitis Aguda
Se caracteriza por la aparición brusca de disuria, polaquiuria y urgencia miccional . Con menor frecuencia se observa incontinencia, tenesmo y dolor suprapúbico que a veces aumenta con la micción (estranguria).
La fiebre debe hacer sospechar la existencia de pielonefritis o de prostatitis.

Diagnóstico:
- Hacer una anamnesis (recoger datos ) de los 3 síntomas principales.
- Si sólo aparece disuria (Dificultad o dolor en la evacuación de la orina), habrá que realizar una tira de leucocitesterasa.
- Se hará UROCULTIVO:
- – Cuando el diagnóstico no esté claro
- – Cuando se sospecha resistencias a antibióticos o fracaso terapéutico
- – Infecciones de repetición
- – Mujeres embarazadas, varones con síntomas, sospecha de pielonefritis
- – Clínica sugerente de ITU y tira negativa
TRATAMIENTO
Hay que tener en cuenta que en España las resistencias de E. Coli son del 65% frente al uso de penicilinas y 35% al uso de quinolonas por lo que será deseable realizar un ANTIBIOGRAMA, para elegir el mejor antibiótico posible sobre todo en el caso de recidivas o racaídas.
El antibiótico de elección será la Fosfomicina trometamol 3g / 1 día. Para los casos de menos de 3 episodios al año. Se tomará el polvo mezclado con abundante agua, mejor 2-3 horas antes de las comidas. Existen otras pautas cortas de 3-5 días con diferentes tipos de antibióticos que siempre deberá prescribir el médico.
Habrá que seguir medidas higiénico-dietéticas de forma estricta. Consisten en el lavado del periné después de tener relaciones sexuales con amplia limpieza vaginal. También se recomienda el vaciado de la vejiga después de mantener relaciones sexuales.

CISTITIS RECURRENTE EN LA MUJER
Es frecuente que la cistitis aguda sea recurrente, debiendo diferenciarse entre recidivas y reinfecciones:
- Recidiva(20%): se debe a la persistencia del mismo microorganismo en la vía urinaria tras el tratamiento de una ITU. Por tanto, se detecta el mismo germen de la infección anterior, y suele aparecer antes de las dos semanas de finalizar el tratamiento previo. Seguir medidas higiénico-dietéticas y terminar pauta antibiótica.
- Habrá que hacer urocultivo y estudio urológico
- Comenzar con pauta analgésica
- Profilaxis antimicrobiana continua
- Reinfección (80%): La reinfección se considera una infección no relacionada con la anterior y aparece después de un mes de finalizar el tratamiento. Suele ser producida por un germen distinto, aunque no es infrecuente que la produzca el mismo germen anterior que persiste en vagina o heces.
- Si se producen 3 o más episodios al año: se tratarán como las recidivas
- Si se produce 1-2 episodios al año: se tratarán como episodios aislados.

¿Cuáles son las opciones sin antibióticos para la prevención de la infección del tracto urinario recurrente?
Las estrategias de prevención no antimicrobianas incluyen el uso de probióticos vaginales, de productos derivados del arándano y la repleción de estrógenos.
los supositorios vaginales de lactobacilos fueron superiores al placebo para prevenir las recurrencias.
RECUERDA EL TRATAMIENTO ANTIBIÓTICO LO RECETARÁ SIEMPRE EL MÉDICO EN LA FARMACIA NO SE DISPENSARÁN SIN RECETA.
PREGUNTA EN LA FARMACIA; SIEMPRE TE AYUDAREMOS Y RECOMENDAREMOS LO MEJOR PARA EL TRATAMIENTO DE TUS INFECCIONES URINARIAS
BY FRL

